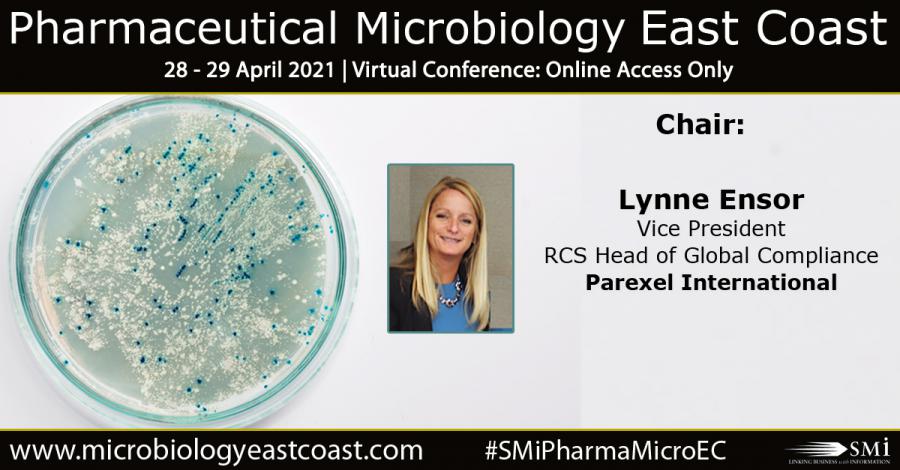
Lynne Ensor, Parexel Chair at SMi’s 4th Annual Pharmaceutical Microbiology

SMi Group Reports: Exclusive interview with Lynne Ensor, Parexel, chairing at SMi’s 4th Annual Microbiology East Coast Virtual Conference, April 28-29 2021.
Source
Lynne Ensor, Parexel Chair at SMi’s 4th Annual Pharmaceutical Microbiology

SMi Group Reports: Exclusive interview with Lynne Ensor, Parexel, chairing at SMi’s 4th Annual Microbiology East Coast Virtual Conference, April 28-29 2021.
Source
Enjoy the top spin wickets of CPL 2023 including the likes of Sunil Narine, Gudakesh Motie, Waqar Salamkheil and Qais Ahmad. Romario Shepherd takes the
Romario Shepherd takes the bails off twice as he runs out Jake Lintott for the Guyana Amazon Warriors against Barbados Royals during the CPL 2021.
Enjoy Chris Gayle’s best innings back-to-back for the Jamaica Tallawahs during the CPL. Subscribe to CPL: http://bit.ly/1EDb4ZH The Republic Bank Caribbean Premier League (CPL) T20
Nicholas Pooran takes a bouncer to the helmet from Sherfane Rutherford but hits a six the next ball while playing for the Trinbago Knight Riders

